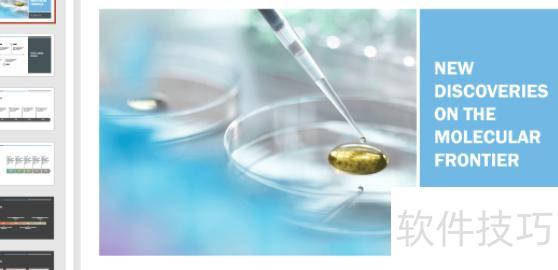
ppt尺寸在哪里设置 ppt尺寸在哪里设置

PPT尺寸设定方法
打开PPT文档,选中需调整尺寸的幻灯片。点击菜单栏中的设计选项,进入后选择幻灯片大小,点击自定义幻灯片大小功能。在弹出的设置界面中,修改为所需的尺寸参数,确认无误后,点击确定按钮,即可完成幻灯片尺寸的调整操作。
我们可以手动调整幻灯片的纵横比。通过点击设计选项卡中的幻灯片大小,能快速在4:3与16:9之间切换,选择自定义幻灯片大小还可设定其他尺寸。更改页面比例后,原有的图片、图形等元素的尺寸和位置可能发生偏移或变形,通常需要重新排版与调整。因此,建议在开始制作PPT前就确定合适的页面比例,以避免后续修改带来的不便。提前设定好尺寸,有助于提升制作效率与整体视觉效果。
在幻灯片大小设置中输入所需的宽度和高度,完成后点击右侧确定按钮,即可完成PPT尺寸设定。
有时PPT尺寸会意外改变,或为提升展示效果,需调整幻灯片页面大小,重新设置PPT尺寸以符合需求。
ppt使用注意:
注意画面布局均衡,选用一至两种字体,字号18-20,颜色与字体总计不超过三种,可借助颜色刷从网络配色方案中提取并应用至PPT。
图片清晰,按需选用三线表或表格模板,图表标注坐标说明,位置恰当,前后附简要总结文字。
设置PPT尺寸:打开文档,选中需调整的幻灯片,点击菜单栏设计选项,进入幻灯片大小功能,选择自定义幻灯片大小,根据需求修改具体尺寸即可完成设置。
新建一个PPT演示文稿后,点击顶部设计选项,选择幻灯片大小。可选标准4:3或宽屏16:9比例,如需其他尺寸,点击下方自定义大小进行设置。
修改PPT尺寸及放映比例时,先点击设计菜单,进入页面设置选项。在页面设置面板中选择幻灯片大小,通过下拉菜单选取所需尺寸,即可完成对幻灯片大小和放映比例的调整,操作简便直观。
调整幻灯片页面大小需在PPT版式设计前手动设置宽度和高度,否则可能导致页面内容变形。
要修改PPT页面尺寸,先打开电脑桌面,启动PPT文件,点击顶部菜单中的设计选项,即可进行页面大小的调整设置。
打开PPT,点击设计选项中的页面设置,进入后可修改页面尺寸与显示方向。
为解决PPT页面尺寸修改问题,先打开电脑桌面中的PPT文件,进入后点击设计选项,即可进行页面尺寸的调整操作。
首先启动Office 2010中的PPT程序,创建一张新的空白幻灯片。完成后,点击顶部的设计选项卡,进入设计界面。在该界面中,找到并点击页面设置按钮,即可进行后续的页面参数调整操作。
新建一个PPT演示文稿后,点击顶部设计选项,选择幻灯片大小。可选标准4:3或宽屏16:9比例,若需其他尺寸,点击下方自定义大小进行设置。
打开PPT文件后,点击顶部的设计选项,进入页面设置。在此可调整PPT的尺寸,点击下拉箭头,选择所需格式,如全屏显示或A4纸张大小等多种预设选项,方便根据使用场景灵活设定幻灯片尺寸。
首先启动PPT2013,进入操作界面。在主界面顶部菜单栏中选择设计选项,点击进入。随后在下拉子菜单中找到幻灯片大小,并点击打开进行设置。
打开文件的设计选项菜单,于属性栏右侧点击页面设置并进入。在页面设置界面中,可调整幻灯片与纸张大小。点开纸张大小选项,选择所需的标准尺寸即可完成设置。
设置PPT尺寸:打开文档,选中需调整的幻灯片,点击菜单栏设计选项,进入幻灯片大小,选择自定义幻灯片大小,在弹出窗口中输入所需尺寸,确认修改即可完成设置。
为调整PPT页面尺寸,先打开电脑桌面,启动PPT文件,接着点击顶部菜单中的设计选项,即可进行页面大小的设置与修改。
点击幻灯片大小下拉选项,选择自定义幻灯片大小。在弹出的设置窗口中,可手动输入幻灯片的宽度、高度,并选择方向。如需特定尺寸,直接填入具体数值即可完成自定义设置。
打开PPT,进入设计选项卡,点击幻灯片大小,可选择标准(4:3)、宽屏(16:9)或自定义尺寸。
在菜单栏中选择设计选项,进入设计选项卡后点击页面设置。弹出窗口后,点击幻灯片大小下方的下拉箭头,在列表中选取全屏幕显示(16:9)或全屏幕显示(16:10),即可完成设置。
打开PPT文件后,点击顶部菜单中的设计选项,进入后选择页面设置。在此可调整PPT的尺寸,点击下拉箭头,从中选取所需格式,如全屏显示、A4纸张大小等,方便根据展示需求进行个性化设置。
打开PPT进入首页,点击工具栏中的设计选项卡,找到并点击页面设置按钮。在弹出的页面设置窗口中,调整幻灯片的宽度和高度至所需数值,确认无误后点击确定完成设置,即可实现自定义页面尺寸。
调整PPT视图大小的方法如下:点击视图选项卡,选择显示比例,在弹出的窗口中设定所需比例后点击确定;也可直接在屏幕右下角通过拖动滑块快速缩放视图,方便灵活地查看幻灯片内容。
在电脑中打开PPT文件后,进入设计菜单并选择页面设置。在设置界面点击下拉箭头,选中自定义选项。随后将宽度设为1、高度设为6,最后点击确定完成设置。























